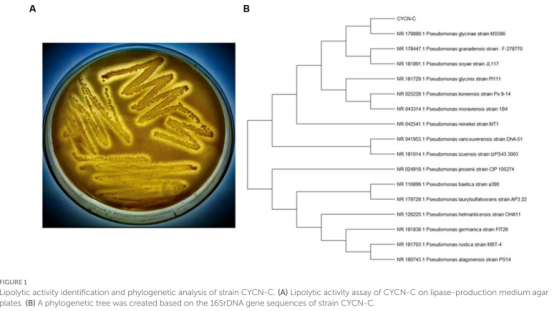

?
近日,浙江農(nóng)林大學(xué)農(nóng)村環(huán)境研究所鄭展望教授團(tuán)隊(duì)在環(huán)境微生物EEM菌種資源研發(fā)與應(yīng)用方面取得重要進(jìn)展,相關(guān)成果以研究論文形式發(fā)表在高水平SCI TOP期刊《Frontiers in Microbiology》(IF=5.2),題為 “New insight into the metabolic mechanism of a novel lipid-utilizing and denitrifying bacterium capable of simultaneous removal of nitrogen and grease through transcriptome analysis”。

餐廚含油廢水中的脂肪、油和油脂(Fat, oil, and grease from kitchen waste , KFOG)如何妥善處置正在全球范圍內(nèi)引起關(guān)注。含油廢水中的KFOG的主要成分是脂肪酸、甘油三酯和脂溶性烴,是造成含油廢水中化學(xué)需氧量(COD)高的主要原因,現(xiàn)已成為水中不可忽視的污染物。水中過量的KFOG會(huì)抑制細(xì)菌的生長(zhǎng)、脂質(zhì)利用效率和脫氮能力,并且難以高效處理。近年來,利用廢棄物做碳源的研究受到廣泛關(guān)注,但是關(guān)于細(xì)菌利用KFOG作為碳源進(jìn)行生長(zhǎng)和脫氮的報(bào)道幾乎沒有,這也限制了這種廢棄物在含油廢水處理中的利用。
針對(duì)上述問題,研究團(tuán)隊(duì)分離并鑒定了一株具有油脂利用和高效脫氮能力的假單胞菌CYCN-C。菌株CYCN-C以KFOG為唯一碳源,TN的去除率可以達(dá)到73.5%。并且利用轉(zhuǎn)錄組技術(shù)分析了菌株CYCN-C分別以KFOG和乙酸鈉為碳源時(shí)的基因表達(dá)情況。結(jié)果顯示,KFOG組中部分基因表達(dá)水平顯著升高,其中包括參與碳代謝的細(xì)胞色素o泛醇氧化酶(cyo)、碳儲(chǔ)存調(diào)節(jié)蛋白基因(CsrA)、聚羥基烷酸酯(PHAs)和延胡索酸酶(FumC)基因分別上調(diào)6.9倍、0.7倍、26.0倍和19.0倍,參與氮代謝的硝酸還原酶(nar)和亞硝酸鹽還原酶(nirB、nirD)基因分別上調(diào)115倍、30倍和49倍,參與脂質(zhì)代謝途徑的脂肪酶(lipA、lipB)、甘油-3-磷酸脫氫酶(glpD)和甘油激酶(glpK)基因分別上調(diào)0.6倍、0.4倍、21.5倍和1.3倍。本研究驗(yàn)證了廢棄油脂作為碳源的可行性,并為該細(xì)菌利用廢棄油脂和脫氮的代謝機(jī)制提供了新的見解。
